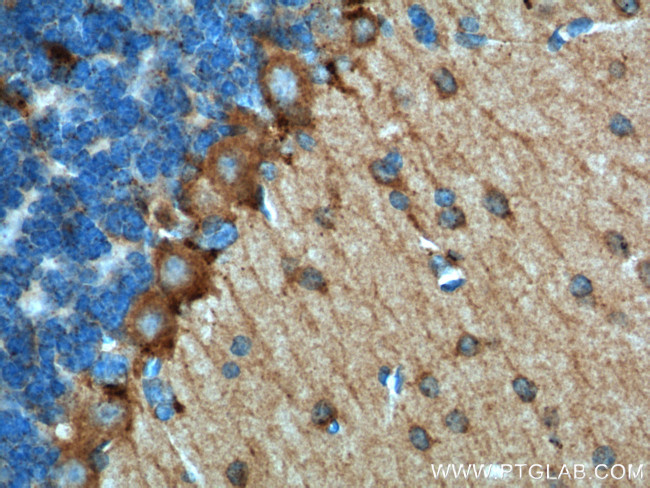
Adenosine A1 Receptor Antibody in Immunohistochemistry (Paraffin) (IHC (P))

Search
Proteintech
Adenosine A1 Receptor Polyclonal Antibody
{{$productOrderCtrl.translations['antibody.pdp.commerceCard.promotion.promotions']}}
{{$productOrderCtrl.translations['antibody.pdp.commerceCard.promotion.viewpromo']}}
{{$productOrderCtrl.translations['antibody.pdp.commerceCard.promotion.promocode']}}: {{promo.promoCode}} {{promo.promoTitle}} {{promo.promoDescription}}. {{$productOrderCtrl.translations['antibody.pdp.commerceCard.promotion.learnmore']}}
产品信息
55026-1-AP
已发表种属
宿主/亚型
分类
类型
抗原
偶联物
形式
浓度
规格
保存条件
运输条件
产品详细信息
The antibody is specific to ADORA1.
靶标信息
Adenosine receptors (ARs) are members of the 7-transmembrane domain G-protein-coupled receptor superfamily. Structural, biochemical and pharmacological analyses of the AR genes and protein has led to the discovery of four distinct AR subtypes (A1, A2a, A2b, A3). Activation of ARs mediates several receptor subtype-specific physiological processes that include cardiac rate, smooth muscle tone, platelet aggregation, inflammation, cell growth and death, and neurotransmission. The A1AR is a glycoprotein that can activate Gi and Go proteins in vitro. In intact cells, agonist occupation of the A1AR has been shown to cause pertussis toxin-sensitive inhibition of adenylyl cyclase activity and, in some systems, a stimulation of phospholipase C resulting in mobilization of intracellular calcium stores. Activation of potassium channels by A1AR has been intensively studied in relation to its dramatic effects on the cardiovascular system. A1AR protein is highly expressed in brain (especially cerebellum, hippocampus, thalamus, and cortex) and spinal cord and in part, modulates neurotransmitter release. In white adipocytes A1AR inhibits lipolysis and stimulates glucose uptake. Other tissues also express A1AR including kidney and testis.
仅用于科研。不用于诊断过程。未经明确授权不得转售。